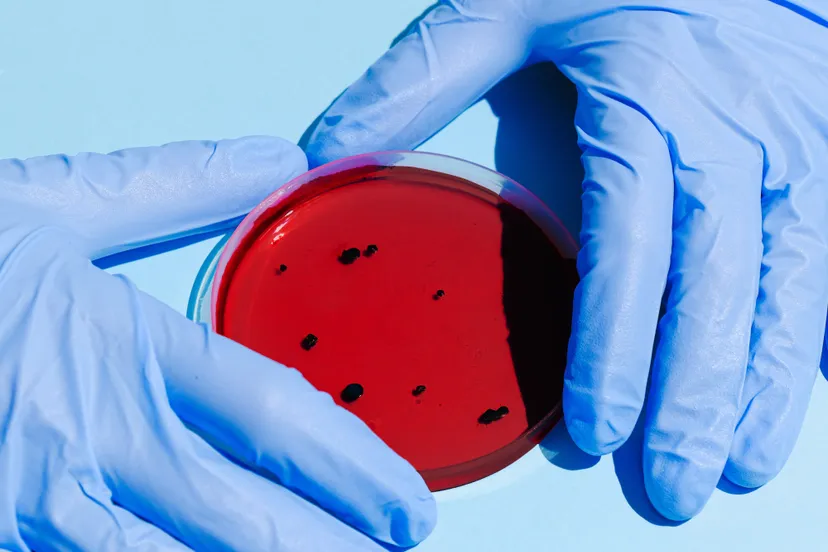
pexels anna shvets 3786217 e1602085115583

Denekamper plaatste wraakporno ex-vriendin op PornHub
08 okt 2020, 10:32 • 112

Mark Mensink
Een 21-jarige man uit Denekamp is veroordeeld tot een werkstraf van 200 uur voor het stalken, belagen en op internet plaatsen van naaktfoto's waarop zijn ex-vriendin te zien is.
Volgens verdachte Jordy P. ging zij al tijdens hun relatie, welke begin 2019 eindigde, vreemd. Reden voor hem om vanaf maart dat jaar haar te belagen, bedreigen en computervredebreuk te plegen. "Ze had op alle accounts hetzelfde wachtwoord", verklaarde de Denekamper bij de rechter. Daarom kon hij overal op haar social media inloggen, meekijken naar wat er geschreven werd en zelf ook diegenen aanspraken. "Ik heb enorm veel spijt. Excuses maken doe ik, maar dat zal ze wel niet accepteren."
Later zette hij ook nog zogeheten wraakporno van de vrouw op pornowebsite PornHub. "Het heeft er vrij kort opgestaan", zei de rechter op basis van het dossier. Desondanks heeft ze veel last (gehad) van alles wat P. deed. "Door de doodsbedreigingen ben ik iedere keer bang als ik een bericht of vriendschapsverzoek krijg", zo las een medewerkster van Slachtofferhulp Nederland namens haar voor. "Het haataccount op Instagram bestaat nog steeds en ik krijg hier nog altijd van bekenden vragen over."
De officier van justitie zei dat P. alle vier de strafbare feiten bekend, drie al tijdens het politieverhoor. "De berichten worden steeds grimmiger, steeds erger. Het is een grove inbreuk op de persoonlijke levenssfeer van het slachtoffer. Hij heeft haar bovendien veel angst aangejaagd door die stalking." Het gaat hierbij om teksten als: "Pas met maar op met wandelen", "Rij jou liever aan dan die hond van je", "Kanker-Downey", "Ik maak je van kant", "Laat je leegbloeden op straat en laat je nooit meer met rust".
Er werd ook nog 3.775 euro aan schadevergoeding geëist. De politierechter wees hiervan 2.000 euro toe op advies van het OM, omdat een aantal strafbare feiten als het ware in elkaar overlopen.
Zijn telefoon, waarmee de berichtjes werden verstuurd, krijgt P. niet terug. Deze zal justitie laten vernietigen.
Loading articles...
Loading